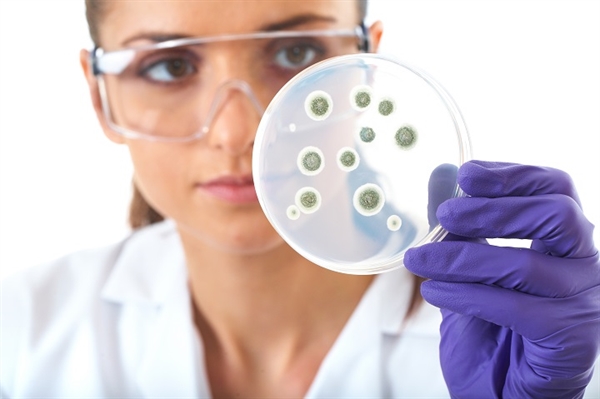

Becoming a medical lab technician – or MLT - is a great way to enter the growing healthcare and medical field. The job is interesting, and it has quite a bit of potential. Many times, the technicians who want to work in this field are going to need an associate’s degree or a postsecondary certificate. Some states require licenses. It is always important to know the rules and regulations in your state.
Duties of a Medical Lab Technician
A medical lab technician will often work directly under the supervision of a scientist or medical lab technologist. The technician is going to be able to employ many of the same tests and procedures that the scientist is able to do.
However, the complex procedures will usually require direct hands-on attention from the scientist or technologist with the MLT working in a support role. Technicians are going to need to be able to communicate well, and they have to have stamina as they may be on their feet for many hours at a time. Techs might analyze body fluids, such as blood, and look for abnormalities. They collect samples, record data, and analyze body fluids, tissue, and other substances.
Those who are working in smaller clinics and labs might find that they have to take care of quite a few different types of jobs, while those who are working in larger labs will often be able to specialize. Some of the specialized areas where technicians might be able to work include clinical chemistry, phlebotomy, microbiology, and immunology. Attention to detail and safety procedures are very important to make sure that they remain safe.